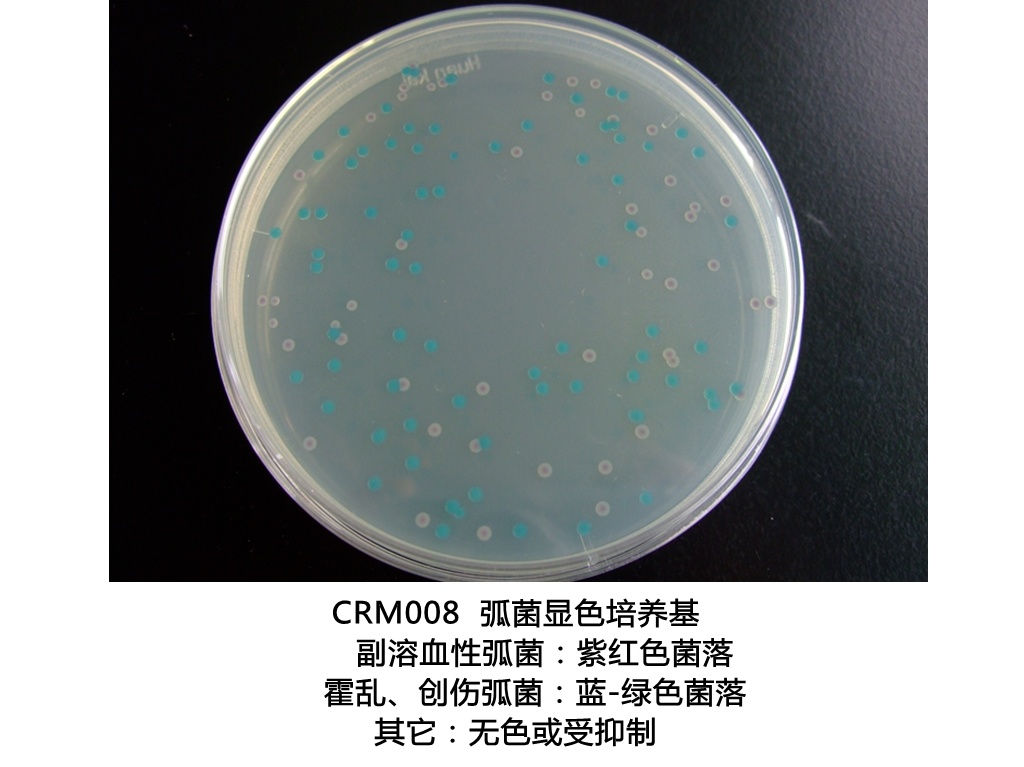
产品细节图片1

相关产品推荐更多 >
万千商家帮你免费找货
0 人在求购买到急需产品
- 详细信息
- 文献和实验
- 技术资料
- 库存:
9999
- 英文名:
Chromogenic Vibrio Agar
- 保质期:
有效期见产品标签
- 供应商:
环凯微生物
- 保存条件:
2-8℃,贮存于避光、干燥处
- 规格:
1000ml/瓶
【产品名称】
通用名称:弧菌显色培养基
英文名称:Chromogenic Vibrio Agar
【产品编号与包装规格】
| 产品编号 |
产品类型 |
包装规格 |
| CRM008 |
干粉 |
1000mL/瓶 |
【产品用途】用于弧菌特别是副溶血性弧菌的分离和初步鉴定。
【检验原理】蛋白胨和酵母膏粉提供氮源、维生素、氨基酸和碳源;蔗糖为可发酵的糖类;抑菌剂抑制大部分非弧菌细菌,氯化钠可维持均衡的渗透压;琼脂是培养基的凝固剂;混合色素与副溶血性弧菌、霍乱弧菌和创伤弧菌所对应的酶发生特异性反应,水解底物,释放出显色基团,在淡黄色平板上产生品红色菌落(副溶血性弧菌)和绿-蓝绿色的菌落(霍乱弧菌和创伤弧菌)。
【配方成分】
| 成分 |
含量(每升) |
成分 |
含量(每升) |
| 蛋白胨 |
18.8g |
琼脂 |
13.0g |
| 酵母膏粉 |
5.0g |
混合色素 |
3.0g |
| 蔗糖 |
20.0g |
抑菌剂 |
1.5g |
| 蒸馏水 |
1000mL |
氯化钠 |
10.0g |
| 最终pH |
9.0±0.2 |
||
【使用方法】称取本品71.3g,加入蒸馏水或去离子水1000mL,搅拌加热煮沸至完全溶解,待冷至50℃左右,在无菌环境中,倾注灭菌平皿,待凝固后,备用。
【质量控制】下列质控菌株接种后于35~37℃培养24h,观察结果如下表:
| 指标 |
质控菌株及编号 |
标准值 |
特征性反应 |
| 生长率 |
副溶血性弧菌ATCC17802 |
PR≥0.5 |
品红色菌落 |
| 霍乱弧菌VBO非01 |
绿蓝色菌落 |
||
| 特异性 |
溶藻弧菌ATCC33787 |
—— |
无色,不扩散 |
| 选择性 |
大肠埃希氏菌ATCC25922 |
G≤1 |
—— |
【储存条件与保质期】2-8℃,贮存于避光、干燥处。贮存期2年。
【注意事项】
1、称量时注意粉尘,佩戴口罩操作以避免引起呼吸道系统不适。
2、干粉培养基使用后立即旋紧瓶盖,避免吸潮结块。贮存于2-8℃,避光、干燥处。
3、质检报告可以登录环凯培养基网站, 打开“下载中心”页面,输入产品批号下载。
【废物处理】检测之后带菌物品置于121℃下高压灭菌30分钟后处理。
【执行标准】Q/HKSJ 03-









风险提示:丁香通仅作为第三方平台,为商家信息发布提供平台空间。用户咨询产品时请注意保护个人信息及财产安全,合理判断,谨慎选购商品,商家和用户对交易行为负责。对于医疗器械类产品,请先查证核实企业经营资质和医疗器械产品注册证情况。
文献和实验规格 Package 念珠菌显色培养基 Chromogenic Candida Agar 用于念珠菌的分离和初步鉴别。 (2010、2015版中国药典) CRM010 1000ml配制用量(干粉) CRM010P1 90mm×20个 (平板培养基
两管庖肉培养基,置 35 ℃±1 ℃,同时接种两管 TPYG 培养基,置 28 ℃±1 ℃,厌氧培养 5 d。检查培养物的浊度、产气、肉粒的消化和产生的气味。若有生长,按步骤 2 分离纯化培养物。若未见生长,则继续培养 10 d。2. 分离纯培养物 取 1 ~ 2 ml 培养液置于无菌试管中,加入等量无菌无水乙醇,混匀,放置室温 1 h。用接种环取 1 ~ 2 环经处理过的培养物在厌氧卵黄琼脂上划线接种,35 ± 1 ℃ 下厌氧培养 48 h。接种可疑菌落到 TPGY 培养基,35 ± 1℃
病学】 病人与带菌者是霍乱的传染源。典型病人的吐泻物含菌量甚多,每ml粪便可含107 ~109 弧菌,这对疾病传播起重要作用。轻型病人易被忽略,健康带菌者不易检出,两者皆为危险传染源。潜伏期带菌者尚无吐泻,恢复期带菌者排菌时间一般不长,两者作为传染源的意义居次要地位。海洋甲壳类生物表面可粘附爱尔托弧菌,后者分泌甲壳酶,分解甲壳作为营养而长期存活。当进食污染海产品后可形成霍乱流行。实验观察,爱尔托弧菌为人工饲养的泥鳅、鳝鱼吞食后,可在后者体内生长繁殖,然后排入水中;因此泥鳅、鳝鱼可成为弧菌
技术资料暂无技术资料 索取技术资料










